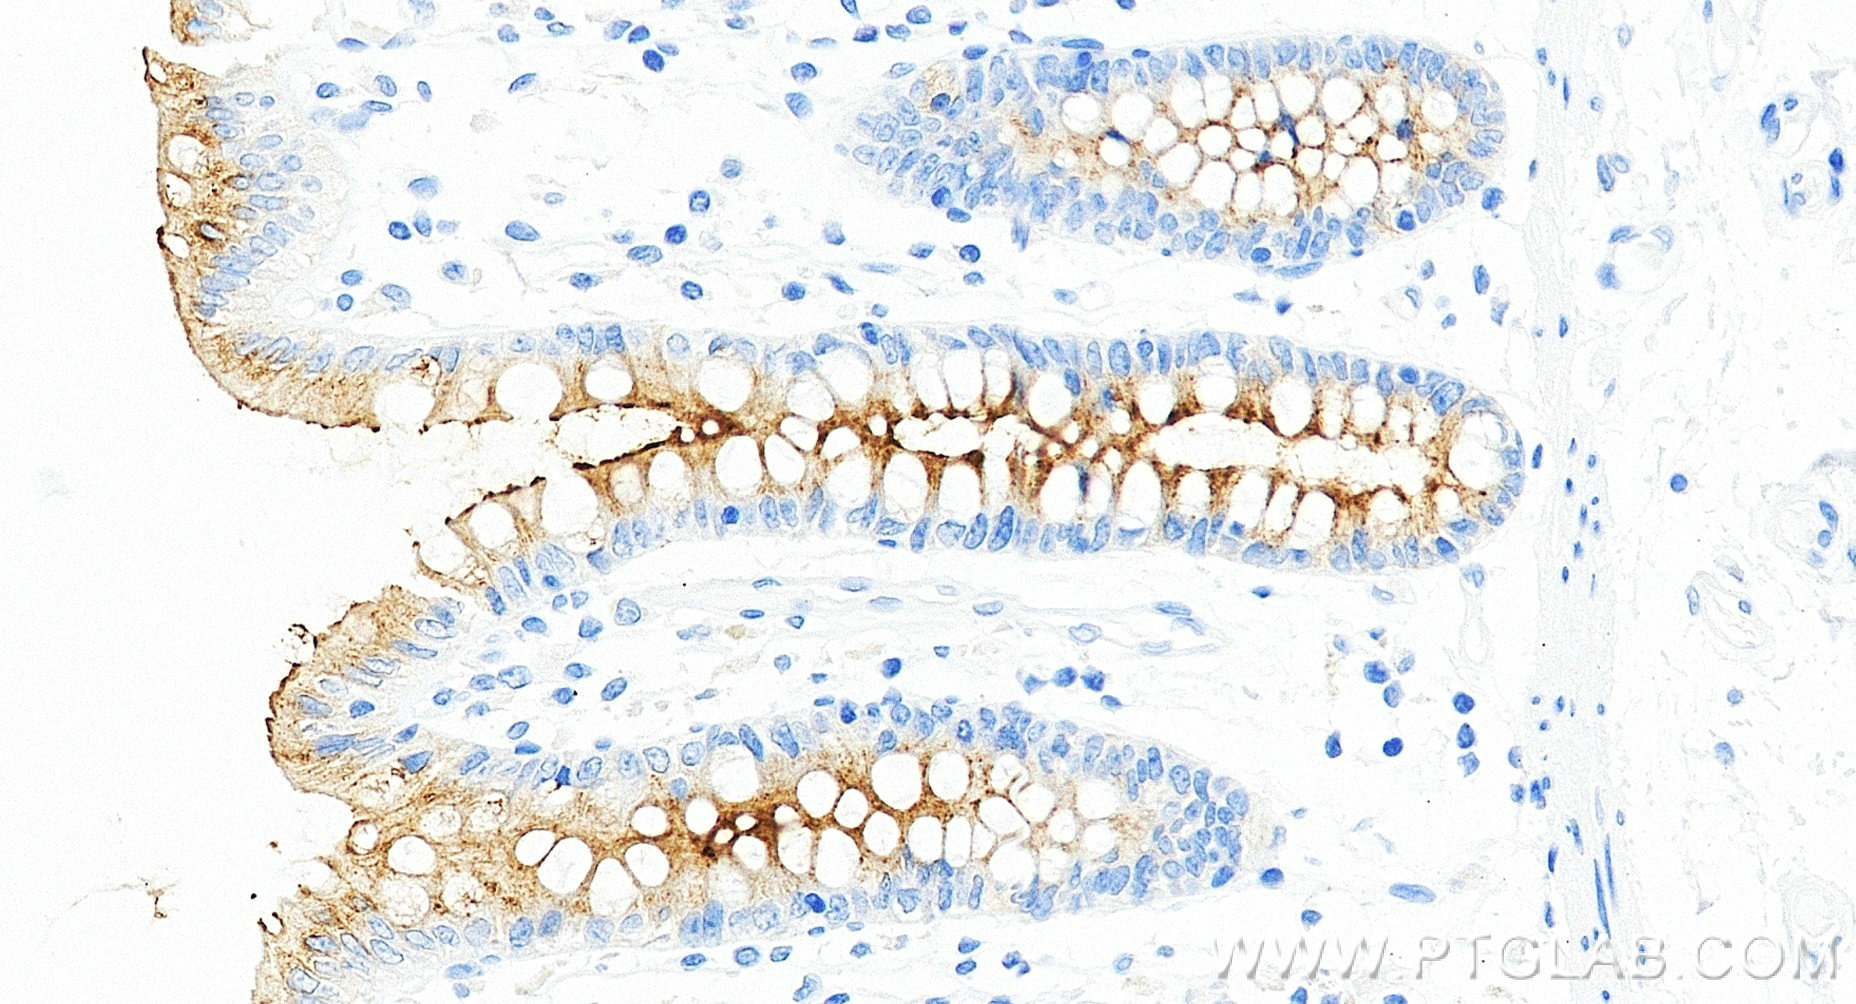
Immunohistochemical analysis of paraffin-embedded human colon tissue slide using 98683-1-RR (MUC13 antibody) at dilution of 1:1000 (under 20x lens). Heat mediated antigen retrieval with Tris-EDTA buffer (pH 9.0). Immunohistochemistry (IHC) staining of human colon tissue using Anti-Human MUC13 Rabbit Recombinant Antibody (98683-1-RR)

Tested Applications
| Positive IHC detected in | human colon tissue Note: suggested antigen retrieval with TE buffer pH 9.0; (*) Alternatively, antigen retrieval may be performed with citrate buffer pH 6.0 |
| Positive FC detected in | HT-29 cells |
Recommended dilution
| Application | Dilution |
|---|---|
| Immunohistochemistry (IHC) | IHC : 1:500-1:2000 |
| Flow Cytometry (FC) | FC : 0.25 ug per 10^6 cells in a 100 µl suspension |
| This reagent has been tested for flow cytometric analysis. It is recommended that this reagent should be titrated in each testing system to obtain optimal results. | |
| Sample-dependent, Check data in validation data gallery. | |
Product Information
98683-1-RR targets MUC13 in IHC, FC applications and shows reactivity with human samples.
| Tested Reactivity | human |
| Host / Isotype | Rabbit / IgG |
| Class | Recombinant |
| Type | Antibody |
| Immunogen |
CatNo: Eg6586 Product name: Recombinant Human MUC13 protein (rFc Tag) Source: mammalian cells-derived, V37 Tag: C-rFc Domain: 19-421 aa of NM_033049.4 Sequence: TNQGNSADAVTTTETATSGPTVAAADTTETNFPETASTTANTPSFPTATSPAPPIISTHSSSTIPTPAPPIISTHSSSTIPIPTAADSESTTNVNSLATSDIITASSPNDGLITMVPSETQSNNEMSPTTEDNQSSGPPTGTALLETSTLNSTGPSNPCQDDPCADNSLCVKLHNTSFCLCLEGYYYNSSTCKKGKVFPGKISVTVSETFDPEEKHSMAYQDLHSEITSLFKDVFGTSVYGQTVILTVSTSLSPRSEMRADDKFVNVTIVTILAETTSDNEKTVTEKINKAIRSSSSNFLNYDLTLRCDYYGCNQTADDCLNGLACDCKSDLQRPNPQSPFCVASSLKCPDACNAQHKQCLIKKSGGAPECACVPGYQEDANGNCQKCAFGYSGLDCKDKFQL Predict reactive species |
| Full Name | mucin 13, cell surface associated |
| Calculated Molecular Weight | 55 kDa |
| GenBank Accession Number | NM_033049.4 |
| Gene Symbol | MUC13 |
| Gene ID (NCBI) | 56667 |
| Conjugate | Unconjugated |
| Form | Liquid |
| Purification Method | Protein A purification |
| UNIPROT ID | Q9H3R2 |
| Storage Buffer | PBS with 0.09% sodium azide, pH 7.3. |
| Storage Conditions | Store at 2 - 8°C. Stable for one year after shipment. |
Background Information
Mucins (MUC) are highly glycosylated proteins that are abundantly expressed in mammalian epithelial cells. Mucin 13 (MUC13) is a member of the transmembrane glycoprotein mucins, which are normally expressed in the large intestine, trachea, kidney, small intestine, and gastric epithelium (PMID: 22027689). MUC13 is involved in the tumorigenesis of multiple malignancies, including pancreatic cancer, colorectal cancer, renal cancer, and lung cancer (PMID: 22027689; PMID: 31427737; PMID: 28205224; PMID: 34966453).
Protocols
| Product Specific Protocols | |
|---|---|
| FC protocol for MUC13 antibody 98683-1-RR | Download protocol |
| IHC protocol for MUC13 antibody 98683-1-RR | Download protocol |
| Standard Protocols | |
|---|---|
| Click here to view our Standard Protocols |